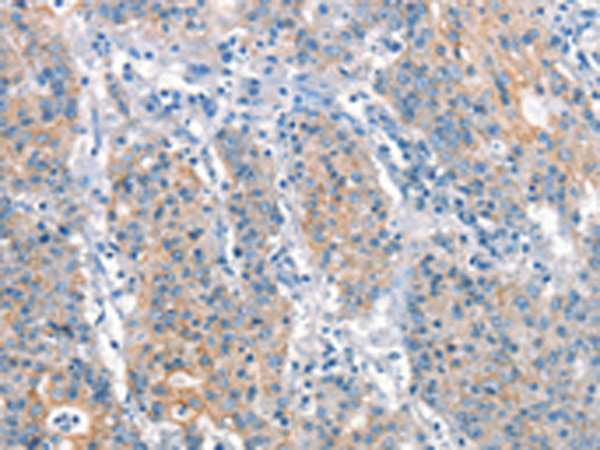

中文名稱: 兔抗ARHGEF11多克隆抗體
|
Background: |
Rho GTPases play a fundamental role in numerous cellular processes that are initiated by extracellular stimuli that work through G protein coupled receptors. The encoded protein may form a complex with G proteins and stimulate Rho-dependent signals. A similar protein in rat interacts with glutamate transporter EAAT4 and modulates its glutamate transport activity. Expression of the rat protein induces the reorganization of the actin cytoskeleton and its overexpression induces the formation of membrane ruffling and filopodia. Two alternative transcripts encoding different isoforms have been described. |
|
Applications: |
ELISA, WB, IHC |
|
Name of antibody: |
ARHGEF11 |
|
Immunogen: |
Synthetic peptide of human ARHGEF11 |
|
Full name: |
Rho guanine nucleotide exchange factor (GEF) 11 |
|
Synonyms: |
GTRAP48; PDZ-RHOGEF |
|
SwissProt: |
O15085 |
|
IHC positive control: |
Human gastric cancer and human thyroid cancer |
|
IHC Recommend dilution: |
25-100 |
|
WB Predicted band size: |
168 kDa |
|
WB Positive control: |
Mouse brain tissue |
|
WB Recommended dilution: |
500-2000 |

購物車
購物車 幫助
幫助
 021-54845833/15800441009
021-54845833/15800441009
